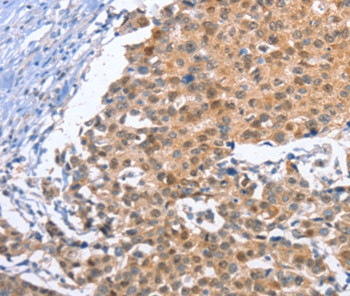
KLF15 Antibody in Immunohistochemistry (Paraffin) (IHC (P))

Search
Invitrogen
KLF15 Polyclonal Antibody
{{$productOrderCtrl.translations['antibody.pdp.commerceCard.promotion.promotions']}}
{{$productOrderCtrl.translations['antibody.pdp.commerceCard.promotion.viewpromo']}}
{{$productOrderCtrl.translations['antibody.pdp.commerceCard.promotion.promocode']}}: {{promo.promoCode}} {{promo.promoTitle}} {{promo.promoDescription}}. {{$productOrderCtrl.translations['antibody.pdp.commerceCard.promotion.learnmore']}}


Please note: We are reviewing Western blot images included in the antibody testing data in our catalog, including those provided by third parties. Unless expressly labeled or annotated as “raw-unedited”, Western blot images included in the antibody testing data in our catalog may have been edited, optimized or otherwise adjusted for presentation.
产品信息
PA5-50232
种属反应
宿主/亚型
分类
类型
抗原
偶联物
形式
浓度
规格
纯化类型
保存液
内含物
保存条件
运输条件
RRID
产品详细信息
The antibody detects endogenous levels of total KLF15 protein.
靶标信息
KLF15 is a nuclear protein belonging to the Sp1 C2H2-type zinc-finger protein family with three C2H2-type zinc fingers. A transcriptional activator, KLF15 binds to the GA element of the CLCNKA promoter and may help to regulate the strict tissue and nephron segment-specific expression of CLCNKA and CLCNKB channel genes. It plays an essential role in adipogenesis in cells through its regulation of PPARG expression. Reports suggest that KLF15 is an inhibitor of cardiac hypertrophy and functions in a pathway, regulating the cardiac response to hemodynamic stress, and regulates mitochondrial acetyl-CoA synthase expression in skeletal muscle. KLF15 may also act as a transcriptional repressor of the rhodopsin and IRBP promoters in the retina, and is a possible participant in repression of photoreceptor-specific gene expression in nonphotoreceptor cells. It is highly expressed in liver, followed by heart, skeletal muscle, and kidney but not expressed in bone marrow or lymphoid tissues.
仅用于科研。不用于诊断过程。未经明确授权不得转售。
篇参考文献 (0)
生物信息学
蛋白别名: DKFZp779M1320; Kidney-enriched krueppel-like factor; KKLF protein; Krueppel-like factor 15
基因别名: KKLF; KLF15
Entrez Gene ID: (Human) 28999